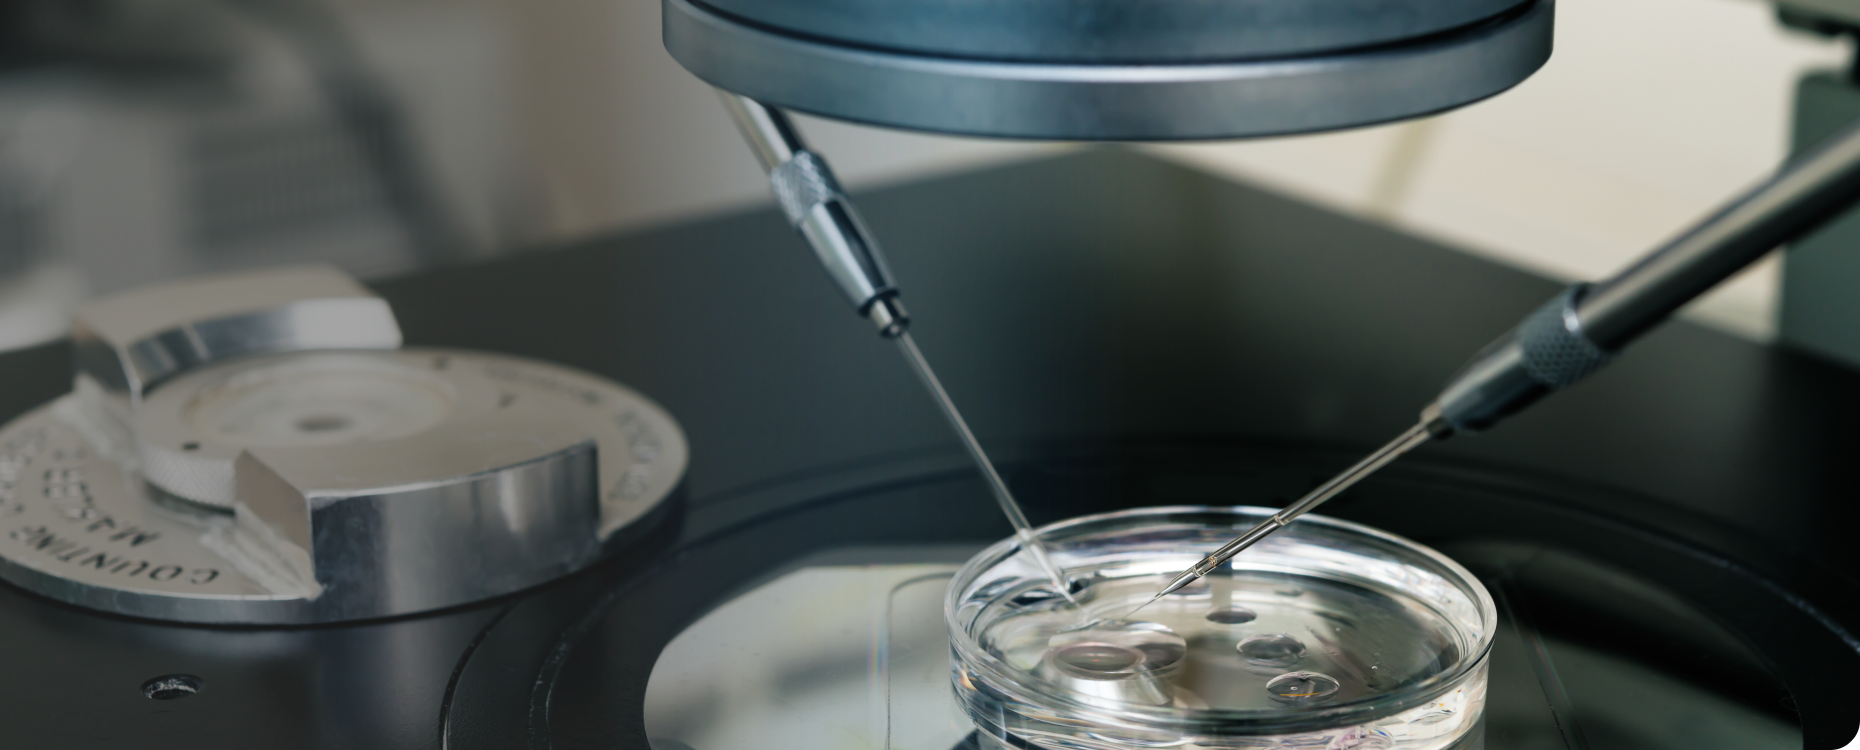
ケン・メディカル株式会社

製品をキーワードから探す keyword Search
お探しの製品をキーワードで簡単に検索できます。製品名はもちろん、用途やメーカー名、カテゴリ名など、思いついた言葉で検索してください。
製品カテゴリ category
医療現場のニーズに応じた多彩な製品を、用途別にカテゴリ分けしてご紹介しています。
産科・婦人科から体外受精、不妊治療まで、専門性の高い製品ラインアップを取り揃えております。
ご希望のカテゴリを選択いただくことで、関連製品をすぐにご確認いただけます。
体外受精関連機器及び
消耗品も取り扱いございます。
(資料、お見積などはお問い合わせフォームよりご依頼下さい。)
取り扱い製品 product
事業内容 business
ケン・メディカル株式会社は、医療機器の輸入・販売をはじめ、IVF/不妊治療領域の専門製品提供、開業サポートなどを通じて、明日の医療を支えるパートナーとして幅広いサービスを提供しています。



医療機器販売事業
国内医療機関の婦人科・産婦人科向けに厳選した高品質な医療機器を提供しています。主に腹腔鏡下手術用器具や子宮頸管拡張器など専門性の高い製品に注力して販売を行っています。
生殖補助医療(ART)支援ソリューション
生殖補助医療(ART)に欠かせない最新機器や管理システムの導入から運用までを一括サポートし、治療現場の効率化と精度向上に貢献しています。
開業サポート事業
新規クリニックの開業準備をトータルで支援しています。
プランニング、院内レイアウト提案、医療機器選定まで全面的にお手伝いさせていただきます。